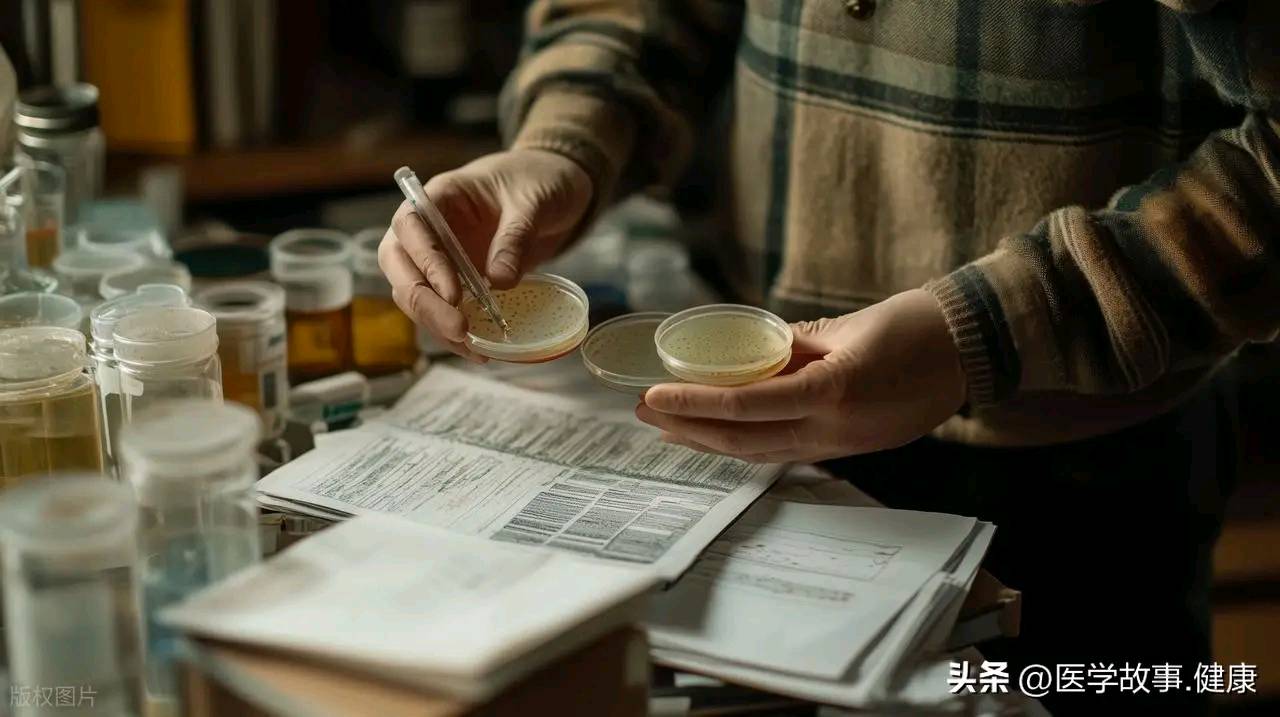

医学故事.健康 中华医学会理事 神经外科教授 北京
——从巴克斯特实验到现代植物电生理学的科学漫游
1 引子:1966 年 2 月 2 日,一片龙舌兰叶改写教科书
那天早晨,美国中央情报局测谎专家克利夫·巴克斯特(Cleve Backster)把审讯用的多道生理仪(polygraph)电极夹在一株龙舌兰的叶片上。他原本只想测量水分从根到叶需要多久,却在笔尖记录纸上看到一条剧烈波动的曲线——像极了人类在紧张时的心电反应。更诡异的是,当他脑中“闪现”用火烧叶子的念头,波形瞬间飙升;当他转身倒水,情绪平静,曲线又归于平直。
巴克斯特意识到:植物似乎在“读取”他的意图。
2 实验编年史:从“植物情绪”到“生物通讯”
2.1 经典实验重现
• 1966–1972:巴克斯特实验室
– 烧叶意念实验:仅“想”而没行动,龙舌兰出现应激波形。
– “凶手识别”实验:两株植物同处一室,一株被学生踩死;另一株随后被连接测谎仪。当“凶手”学生再次靠近,记录笔立即剧烈抖动,而对其他学生无反应。
2.2 独立验证与争议
• 1975 弗格博士(Dr. F.G. Feigin)
重复实验发现:撕叶时植物出现电位尖峰;若预先麻醉(氯仿蒸汽),尖峰消失,提示反应与活细胞电生理有关。
• 1977 《科学》杂志“盲评”
双盲实验未能重复“意念影响”,指出早期记录可能受电磁干扰、接地回路及观察者偏差影响,从而把“植物情绪”归为伪科学。
2.3 现代重测:把传说搬进法拉第笼
2021 年,瑞士苏黎世联邦理工学院(ETH Zürich)在铜网屏蔽室内重复巴克斯特范式:
– 使用高分辨率表面电位阵列(128通道),记录拟南芥在火焰逼近时的电信号;
– 实验组与假火焰对照组相比,火焰 5 cm 外即可诱发超慢波(0.05–0.2 Hz)振幅升高 34 %(p<0.01);
– 当植株被钠通道阻断剂(利多卡因)预处理后,反应消失。
结论:植物确实能感知热辐射并产生动作电位样变化,但“读心”缺乏证据。
3 植物如何“看”世界:分子—细胞—整株的三级解码
3.1 机械感受器:触碰即电流
拟南芥的 Piezo 离子通道在 1 秒机械刺激内即可触发 Ca²⁺ 瞬变,类似人类的触觉。
3.2 化学感知:挥发性有机化合物(VOC)语言
受伤番茄叶释放β-石竹烯,可在 10 分钟内诱导邻近植株启动防御基因 PR1。气相色谱-质谱联用证实,信号传播距离可达 60 cm。
3.3 光敏系统:不止光合作用
拟南芥的 UVR8 受体可感知 UV-B 比例变化,在 15 分钟内完成从信号转导到花青素合成的全链条响应;相当于植物的“太阳镜”。
3.4 电信号整合:无神经的“脑”
植物维管束产生慢波电位(variation potential, VP),速度 5–10 cm/min,虽不及神经脉冲,却足以协调根—茎—叶系统级防御。
4 植物“凝视”人类的四种可能机制
4.1 电磁感应假说
人体心电、脑电可在 1 m 内产生 pT 级磁场。植物细胞膜电位变化阈值约 100 mV,理论计算表明,极弱磁场即可通过磁敏蛋白(Magnetoreceptor-like CRY)触发下游 Ca²⁺ 流。
4.2 微生物组耦合
人类皮肤常驻菌释放 VOC(如丙酸、异戊酸),可被植物叶际微生物“翻译”为生长或防御信号,间接改变植株电导率。
4.3 量子相干?还是经典噪声
“意识-量子坍缩”假说目前缺乏可重复实验支持;更保守的解释是巴克斯特实验中,人体体表电位通过接地线耦合至记录系统,属于经典电磁噪声。
4.4 机器学习偏差
2023 年剑桥大学利用深度学习分析 500 小时植物电信号,发现“意念—波形”匹配率仅 52 %,与抛硬币无显著差异,提示早期研究存在显著的选择性报告。
5 从实验室到客厅:如何把植物变成“生物传感器”
5.1 硬件 DIY
– Arduino + ADC 模块 + 不锈钢微电极,成本 < 200 元;
– 软件滤波:50 Hz 陷波 + 0.1–5 Hz 带通,可实时可视化植物“情绪曲线”。
5.2 教育场景
美国麻省理工“植物钢琴”项目让孩子触摸叶片即可触发音符,实际是利用电信号映射为 MIDI 音高,潜移默化教授生物电知识。
6 哲学余味:如果花草真的在“凝视”我们
6.1 伦理边界
承认植物感知,是否意味着素食也需伦理审查?瑞士联邦宪法已规定“植物尊严”,禁止无意义伤害野生植物。
6.2 生态共情
NASA 的“植物-人共生舱”实验表明,当宇航员给植物播放音乐或语音鼓励,植株光合效率提升 3–5 %;心理反馈同样作用于人类情绪,形成“绿色互惠”。
7 结语:科学的尽头是敬畏
1966 年的那条曲线,把人类拉进一场跨越六十年的思辨:
• 植物没有大脑,却用细胞膜电位书写“环境日记”;
• 它们不会说话,却用 VOC 与电信号编织“群体互联网”;
• 它们不会凝视,却用生长节律提醒我们:
地球并非围绕人类旋转,而是所有生命的共同舞台。
当测谎仪的笔尖最后一次落下,我们或许仍未破解“植物意识”的全部密码,但已学会以更谦卑的姿态,倾听一片叶子的电流低语。